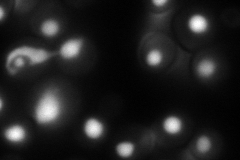
YOR148C
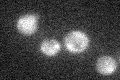
YOR148C
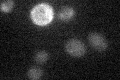
YOR148C

View description
Essential protein that promotes the first step of splicing and is required for the final stages of spliceosome maturation; interacts with Prp2p, which may release Spp2p from the spliceosome following the first cleavage reaction
Localization:
Intensity:
Fold change:
Significance:
-
C’ GFP library in SD

below threshold16.96 -
N' NOP1pr-GFP in SD
nucleus116.221 -
N' TEF2pr-mCherry in SD

nucleus188.656 -
N' NATIVEpr-GFP in SD

nucleus19.9588 -
N' TEF2pr-VC and Cyto-VN in SD

#N/A0 -
C’ GFP library in SD+DTT

cytosol14.470.85No -
C’ GFP library in SD+H2O2
cytosol16.610.97No -
C’ GFP library in Starvation Media
cytosol17.671.04No -
C’ GFP library on the background of Pup2-DaMP

below threshold -
C’ GFP library on the background of CCT mutant

below threshold17.13111.00967No
